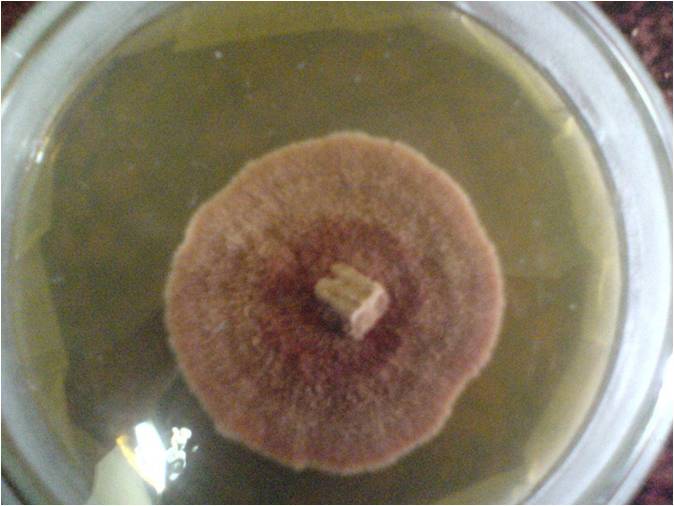

服务热线
- 133-7643-2729
- 139-2513-3579
牛樟芝三种培育方法
文章作者:宏珍宝 发布时间:2020-11-07
由于野生牛樟芝在民间应用时所产生的惊人疗效以及野生原料资源枯竭,不但使得其价格高涨、并且激发了台湾政府及各大研究机构、生技公司的强烈兴趣。一时之间,各种利用生化技术培育樟芝的研究成为台湾最为红火的生化科技项目。在台湾,对于牛樟芝人工培育大致可以分为椴木栽培法、固体培养法、液体发酵法三种。
固体培养法:
将牛樟芝菌种以太空包进行菌丝体培养。太空包含有纤维物、醣类、五谷杂粮类等;培养时间约三个月;培养成本稍高。缺点:三萜类含量低,功效差,不利于推广。

液体发酵法:
利用500公升甚至吨级以上的液体发酵槽进行菌种液体发酵以收取菌丝体;培养时间短,约七至十四天左右;无法取得野生樟芝特有的三萜类。缺点:无三萜类含量,功效差,不利于推广。

椴木栽培法:
利用樟芝原有宿主牛樟树或其他椴木(树龄都在80年以上的椴木)为培养基栽培牛樟芝;能获得与野生牛樟芝相同之成分,功效相同,避免野生牛樟树被盗伐;培养时间大约2年。
这就可以解释为什么市场上有些牛樟芝产品非常便宜了,因为采取的栽培方法不一样,产品的成本也不一样,所以很多卖的很便宜,却没有任何功效。目前来讲,功效最强,认可度最高,台湾本地人最认可的还是椴木栽培法培育出的可以跟野生牛樟芝相媲美的牛樟芝子实体。
(此资讯来源于百度及互联网)




